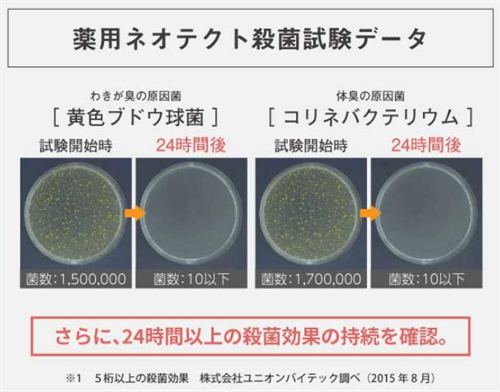

この記事では薬用ネオテクトの口コミや私が使って感じた効果について紹介しています。
薬用ネオテクトは厚生労働省が効果を認めた有効成分入りの薬用デオドラントクリーム。
ネットやSNSでの反響が多くニオイケアが手軽にしかも消臭効果が高いことで知られています。
そこでこのサイトでは薬用ネオテクトの口コミ情報を徹底解剖し、どんな商品なのか詳細を検証いたします。
効果については実際に使用してみた結果をご紹介しますので、購入を迷っている方はぜひ参考にしてください。
\ 初回限定 2,980円 /
目次
- 1 薬用ネオテクトの口コミ評判・ユーザーの意見を参考にしておこう!
- 2 薬用ネオテクトの口コミは嘘?効果なしの悪い口コミ
- 3 薬用ネオテクトは効果ありの良い口コミ
- 4 薬用ネオテクトの口コミまとめ
- 5 薬用ネオテクトのインスタグラムでの口コミ
- 6 ネオテクトのAmazonでの口コミ
- 7 薬用ネオテクトの効果について実際に使った私の口コミをご紹介
- 8 薬用ネオテクトが口コミで高評価!人気の3つの理由
- 9 薬用ネオテクトの使い方とニオイケアのポイントについて
- 10 薬用ネオテクトのメリット・デメリットがあるので理解してから購入しよう!
- 11 薬用ネオテクトをおすすめしない人はこんな方・よく考えてから判断!
- 12 薬用ネオテクトをおすすめする人・こんな場合は満足!
- 13 薬用ネオテクトの成分と副作用のリスクについて知っておきたいこと
- 14 薬用ネオテクトQ&Aのまとめ・よく寄せられる質問はこちら!
薬用ネオテクトの口コミ評判・ユーザーの意見を参考にしておこう!

実際に利用している方や体験した人がどう感じたのか、口コミ評判を色々と集めました。
効果に満足されていない口コミ
- コスパが厳しいと感じた。
- ニオイを完全に抑えられなかった。
- デオドラントとしての機能は評判ほどではない。
- かなり量を使わないと効果がなかった。
効果に満足されている口コミ
- 旦那のおじさん臭がなくなった。
- 高校生の息子のワキガが軽減した。
- デリケートゾーンと足に使用し、効果を感じた。
- 一日中ニオイを気にせず過ごせた。
- 米粒程度の量で効果があったと感じた。
※個人の感想であり効能効果を表すものではございません。
薬用ネオテクトの口コミは嘘?効果なしの悪い口コミ
まずは、効果に満足されていない口コミを見ていきましょう。
コスパが厳しいかなーと思いました!
デリケートゾーンのニオイケアに購入しました。
クリームタイプは初めてでべとつきがなく伸びも良いので商品としてはとてもいいと思います。
1日効果があるのでいいですね。
逆にこの値段なのでこれぐらい効果がないと…と感じるコスパなので、かなり期待して使うとがっかりする人もいそうです。
完全にニオイを抑えるってほどではなかった…
テクスチャーは私好みでサラサラに仕上がる。
容器もシンプルなデザインでいい。
ただでデオドラントとしての機能は評判になっているほどではないと感じた。
ワキに塗ったけど昼過ぎには少し臭ってきたので市販のスプレーよりかいい、というレベル。
また買うかどうかちょっと迷う商品。
膜をはったような密着感が慣れるまでに時間がかかった。
かなり量を使わないと効果がなかったです
少しだけでよく伸びるというので試しに使ったけど、結構量が必要でした。
ちょこんと指先にのせるぐらいではまったくワキガには対抗できず結局なんどか塗りなおすと1本あっという間。
安いデオドラントではないのでその点が気になった。
※個人の感想であり効能効果を表すものではございません。
薬用ネオテクトは効果ありの良い口コミ
効果に満足されている口コミを紹介します。
旦那のおじさん臭がなくなりました!
娘にいつもくさいと文句をいわれていたので、家でこんな状態なら会社ならかなり周りに迷惑をかけているのではないかと思い、ネットの口コミ情報を信頼して薬用ネオテクトを購入しました。
朝首に塗っておくと家に帰ってきたときに軽く臭う程度まで軽減しました。
いつもコロン(これもおじさん臭い!)でごまかしていましたが、体臭と香りが混ざったおかしな臭いもなくなりよい商品に出会いラッキーでした。
塗ったときと塗らないときでは全く違う
毎朝高校生の息子に塗らせています。
部活で運動しているので家に戻ってきたときはかなり強烈なワキガがします。
ネオテクトを使った日は洋服も無臭、使わない日との差がものすごいです。
朝と夜2回使うようですが息子はめんどくさがり朝だけ。
それでもかなり効果があります。
デリケートゾーンと足に使用しています!
会社でオフィスの用の靴にはきかえるときにニオイがとても気になっていました。
デオドラントのシートタイプでふいたりしたけど効果なし。
こんな便利なクリームがあるならもっと早く買えばよかったです。
デリケートゾーンにも使えるので最近人に近づいても怖くないです。
自分のニオイを気にせず日中過ごせるようになりました
ちょっと過敏になりすぎているかな、と思うぐらい自分のニオイが心配でした。
長いことほかのデオドラントスプレーを使ってましたが、何度も使わないといけないし夜遅い日はかなりニオイが激しくなるので違うものにしようとずっと思っていたときです。
口コミもよく値段もそれなりですが一度試してみようと思い買いました。
一日ニオイを気にせず過ごせるようなったのは薬用ネオテクトのおかげ。
心まで軽くなり感謝です!
あのツーンとした嫌な臭いがなくなりびっくり!
洋服にもずっとにおいが残るほどかなりひどいワキガです。
安い商品ではまったく効果がないのでこちらを試しに使ってみました。
評判通りにニオイがなくなり驚きです。
米粒程度の量でここまでできるなんて、コスパも悪くないと思います。
※個人の感想であり効能効果を表すものではございません。
薬用ネオテクトの口コミまとめ
気になる口コミとしては値段に関して指摘している方がいましたが、薬用ネオテクトは確かにドラッグストアやスーパーで売っている一般的なものよりも値段は高いです。
薬用クリームで効果効能が認められた成分を使っているのでコストが高いのは仕方ないかもしれませんが、1本で全身対応、少量で伸びやすいといったことを考えるとコスパも使い方によっては悪くないでしょう。
良い意見ではニオイが軽減したというユーザーがとても多く、ほかにもさらさらの使用感を評価されている方も多いです。
制汗作用については色々ですが、かなり良い印象を受けました。
\ 初回限定 2,980円 /
薬用ネオテクトのインスタグラムでの口コミ
インスタグラムでの口コミを見ていきましょう。
この投稿をInstagramで見る
![]()
体臭は年齢とともに強くなる気がしませんか。
汗をかいた後のムレた洋服など人に近づけないほど不安になる場面がありますよね。
そんな方には薬用デオドラントでしっかり全身のニオイケアがおすすめ。
ネオテクと歯殺菌効力試験済みであらゆる部位に使えるので活用シーンが色々ありますよ。
この投稿をInstagramで見る
![]()
この消臭制汗クリームは本当に効果的で、夏の汗のニオイに悩む人におすすめです。
全身に使えるので、足や脇などどこにでも使えるのが便利です。さらに爽やかな香りで癒される上に、制汗効果もあるので汗をしっかり抑えてくれます。
この投稿をInstagramで見る
![]()
ニオイはワキガやデリケートゾーンなど色々困るところがありますよね。
足のニオイも油断すると恥ずかしい場面があり、女性の場合はストッキングでムレてしまうことも。
オシャレなパッケージのクリームタイプのデオドラントなのでさっと塗布して不安解消してください。
この投稿をInstagramで見る
![]()
デオドラント効果が長時間持続するものは肌に刺激があるなどデメリットも多いですよね。
その点ネオテクトは殺菌効果が非常に高いわりには肌に優しく、汗で流れることもなし。
無臭なので香水との相性も良い点はオシャレしたい日でも安心して使える理由になりますよ。
ネオテクトのAmazonでの口コミ
Amazonの口コミ評判をご紹介します!
| 特長 | 詳細 | 対策や使用法 |
|---|---|---|
| 消臭効果 | 高い消臭効果、時間が経っても効果持続 | 朝晩の使用が推奨、特にシャワー後に使用 |
| 使用部位 | 鼻、首、脇、胸周り、足、背中、うなじ等 | 使用部位によって量を調整、全身に使える |
| 価格 | 高め | 価格に見合った効果があると多くのユーザーが感じる |
| 持続時間 | 一日中効果が感じられる | 朝に一度塗ると帰宅時まで効果あり |
| 肌への影響 | 低刺激、肌荒れなし | 脱毛後の肌にも使用可能 |
| 個人差 | 効果に個人差はあるが多くの人が効果を実感 | 加齢臭、ワキガ、足の臭い等、様々な臭いに対応 |
| 使用感 | 若干ヌルヌル感がある | 塗った後、さらさらになるまで待つと良い |
| その他 | 厚生労働省認定成分使用、日本製 | 制汗スプレーとは異なり、ニオイの原因菌を抑える |
| 使い方 | クリームタイプを塗り広げるだけ | 朝晩、特にシャワー後に使用が推奨 |
デオドラントとは次元の違う効き方
若干、脇の匂い等が気になり、これまでデオドラントでなんとかしのいできました。
ボールで塗るリキッドタイプや、粉末をこすりつけるタイプ、ソフトストーンを塗り込むタイプ色々なものを使いましたが、どれも塗った直後はすごくいいんです。
ただ、時間がたつにつれて、デオドラントの匂いと脇の匂いが科学反応を起こして、また別の匂いが発生するという問題が起きるのです。
ただ、このクリームは全く別もので、塗り込んだからといって爽やかな香りなどはしませんが、確実に体に浸透し、副産物的匂いも発生させません。
お値段が安くないだけあって、効果はあるようです。引用:Amazon
![]()
厳選した成分を使用しているのでお値段は一般的な商品よりも高いです。
しかし安いデオドラントで肌荒れになったり、何度も塗りなおしする手間を考えると確実に効果を発揮するものが一番安心して使えると思いますよ。
個人差はあるかもしれませんが
数回利用しています。
加齢臭対策で購入しました。
私には合っているようで、このクリームを朝のシャワー後に塗ると、一日中効果を感じることができました。
使用箇所は鼻、首、脇、胸まわりです。
特に鼻に、このクリームを少量塗ると、効果てきめんです。
マスク生活で、鼻から脂臭が漂って不快感を感じていましたが、嘘のようになくなりました。
毎日使用して約1ヶ月ほど持ちます。
いい商品ですがお値段が高いのが残念です引用:Amazon
![]()
全身に使えるデオドラントクリームで肌に安全です。
鼻に塗る方法は意外なアイデアかもしれませんが、不快感を軽減するメリットが多いでしょうね。
加齢臭は自分の年齢がさらに気になる原因になりますので、ニオイの発生源になりやすい首やワキ、などにしっかり塗布してお出かけください。
汗かいても臭いが気にならなくなりました!
子供と夫の臭いが気になりこちらを購入しました。
市販のデオドラントではあまり持続効果がなかったのですが、こちらのクリームは持続効果が長いようで朝塗って出て帰宅しても汗の臭いもですが、ワキガのあの独特の臭いも気にならなくなる程抑えてくれてとてもよかったです!
これから夏になるにつれて、ワキガ臭は特に気になり周りにも不快な気持ちにさせるので、こちらのクリームを買ったおかげで周りもハッピーになり助かるのでいい買い物かなと思っています!
ただ、価格が高いので一本で二人が使ってどのくらいまで持ってくれるのか懐柄不安です。
また1度出したら戻せないので子供だと出す量の調節も注意が必要です。引用:Amazon
![]()
塗布する部位によって量の調整は必要ですが、多少多くても肌に負担はないので安心して使えます。
お子様にも使える低刺激なデオドラントなので家族皆さんでぜひ愛用してください。
値段相応に消臭力あります。
クリームタイプのデオドラントとして、価格帯はたしかに高め。ただ、相応の効果は実感できました。
「ワキガ」対策ようではありますが、足の臭い対策にも使っていけそうです。
冬場はブーツで長時間出歩くこともありますが、本品使うとムレても臭いがキツくならない。
確かに効果は実感できました。塗ってからしばらくの間ややヌルヌル感が残るのが難点かな・・・。
引用:Amazon
![]()
クリームを塗布して皮膚の表面にまだ残っていることがありますのでしっかり抑えこんで、さらさらになってから洋服を着用するといいかと思います。
ブーツは吸汗性も通気性も悪いためニオイがとても心配になりますが、ネオテクトは制汗作用もあるのでじめっとした感触も減ると思いますよ。
厚生労働省から効果を認められた有効成分配合のデオドラントクリーム
私は元々わき脱毛をしていて、それから大量のわき汗をかくようになりました🙄💦
脱毛していなかった時はそこまでわき汗はきにならなかったのですが、、😂そこでネオテクトを使ってみました💕
クリームタイプを塗り広げるだけですが、全く違和感なく使えました☺️わき汗はをたくさんかくようになってから、汗のニオイも気になっていたのですが、夜お風呂上がりにつけると翌日は汗のニオイが気にならなくなりました❣️
さらに、かく汗の量も減ってTシャツに汗のシミがつくことがなくなりました💮🥺✨厚生労働省から効果を認められた有効成分 フェノールスルホン酸亜鉛(制汗)、シメン-5-オール(防臭)のハイブリッド処方でニオイ発生の根本原因を抑えるそうです❣️🤓✏️
ニオイの元となる原因菌かま24時間経っても増えずらかったという試験データも有ります🥸
💎ウォータープルーフ
💎天然成分配合で保湿、黒ずみケアわき、足、首もと、背中、うなじにも使えます😌✨
使用目安は朝晩⭐️
制汗スプレーは粉で汗を押さえつけるので、一時的には汗を抑えれてもニオイは止まらないそうです📝
日本製なのも安心感✨🇯🇵
とてめ使い心地が良く、肌に負担がなかったのでこの夏はこれ1本で制汗、消臭していこうと思います💙😁
引用:Amazon
![]()
脱毛後は汗腺が露わになり汗をたくさんかいているように感じることがあります。
ネオテクトは有効成分入りで防臭、制汗作用がある薬用デオドラントクリームです。
1日2回の使用で脱毛後の肌も安定しニオイケアもばっちりできますので、ぜひ継続使用してもっと効果を実感してみてください。
\ 初回限定 2,980円 /
薬用ネオテクトの効果について実際に使った私の口コミをご紹介

薬用ネオテクトは本当にわきがや体臭予防に効果大なのか、実際に使って検証してみました。
個人的に感じたことですが、デオドラントの効果をまとめます。
| 項目 | 口コミの詳細・感想 |
|---|---|
| 対象者 | 50代主婦、ワキのニオイが気になる |
| 商品の形状 | チューブ入り、細い先端、白いクリーム |
| 使用感 | 密着感があり、肌になじむ、さらっとして清涼感あり |
| 防臭効果 | 夕方のニオイが気にならなくなった、効果持続時間は8時間程度 |
| 汗の減少 | 汗自体が少し減ったと感じる |
| 使用部位 | ワキだけでなく全身に使える |
| 購入のきっかけ | 友達の勧め、口コミで評判が良かった |
| 殺菌効力と使える部位 | 殺菌効力がほぼ100%、粘膜以外なら全身使える |
| 価格とコスパ | 伸びが良く、コスパはそれほど悪くないと感じる |
| 総合評価 | 普通のデオドラントより効果の持続時間が長い、低刺激、肌荒れなし |
肌に密着するテクスチャーのクリーム!
私の悩みはワキのニオイ。
ワキガってほどではないと思うのですが汗をかくと数時間後にムっとしたニオイが発生する50代主婦です。
40代よりも50代のほうがニオイが少し気になるかなーという感じ。
いつもはスティックタイプを使っていました。
薬用ネオテクトはチューブ入りで先端は細くクリーム量は調整しやすいです。
白いクリームで肌に伸ばすと透明になり接着剤みたいな密着感がありました。
しっかり肌になじませるとさらっとしてすこし清涼感があります。
夕方のニオイが気にならなくなった!
クリームを塗るときに肌を清潔にしているためか、塗布直後の防臭効果については私はあまりわかりませんでした。
ただいつも夕方ぐらいになると洋服のなかからムっとニオイがこもるあの嫌な不快感はすぐになくなりました。
今まで使っていたスティックタイプのデオドラント以上の効果は実感できます。
体臭が強い人ならクリームを塗ったときに違いはわかると思うので試してみる価値はありそうです。
クリームなので肌に成分が浸透していると実感できます。
汗が減ってきました!
薬用ネオテクトを使い続けて感じたことはニオイはもちろんですが、原因になる汗自体が少し減ってきたことです。
ワキに汗ジミができることがありましたが最近は気にならないぐらいまで減ったと思います。
少し急いで歩いたときや家事をやっているときなど、私の場合はワキとバスト周辺に汗をかきやすいです。
これ1本で全身に使えるので伸びがよいテクスチャーで色々な部位に使える点もなかなかいいですね。
ニオイは菌の発生が原因なので制汗作用が高いことはワキ汗以外でも汗をかきやすい部位にもメリットがありそうです。
薬用ネオテクトは口コミで評判が良かったので購入しました
色々なデオドラント商品がありますが、実は薬用ネオテクトというものはネットで検索するまで知りませんでした。
クリームタイプがいいと友達から教えてもらい、たまたまリサーチしたところヒットしたのがこの商品。
どんな評価かチェックしてみたらとても良かったので使ってみることにしてみました。
すごいなと思ったのは殺菌効力がほぼ100%近いことと粘膜以外なら全身使えるマルチタイプであること。
夫も一緒に使えそうなのでこれに決めました。
薬用ネオテクトを使ってみた私の感想まとめ
総合的な感想です。薬用ネオテクトはべたつきがなくさらっとしてすぐに洋服が着れることや、使いやすく伸びやすいのでコスパもそれほど悪くないと思います。
ワキガやワキ汗、加齢臭など色々な防臭に効果があるのはナノ化した成分のおかげかなと思います。
あきらかに普通のデオドラントよりも効果の持続時間は長く、しかも肌荒れなどがなく低刺激。
私の場合は8時間ぐらいは効果を感じました。
容器もオシャレなのでニオイケアのテンションがあがる商品ですよ。
\ 初回限定 2,980円 /
薬用ネオテクトが口コミで高評価!人気の3つの理由
薬用ネオテクトはなぜ口コミがこんなにいいのか疑問に感じると思いますので、人気の3つの理由について詳しく解説いたします。
| 主なポイント | 詳細説明 |
|---|---|
| 効果効能が認められた成分 | 有効成分「シメン5オール・フェノールスルホン酸亜鉛」により、ワキガや加齢臭を抑制。厚生労働省からも認められている。 |
| 高密着テクノロジー | ナノ化したマイクロクリームが肌に密着。ウォータープルーフで持続力が高く、汗を何度も拭き取る必要がない。 |
| 肌に優しい成分 | 天然由来エキスで肌荒れの心配が少ない。茶エキスやドクダミエキスなどの自然成分、さらにプラセンタエキスやヒアルロン酸も配合。 |
効果効能が認められた成分を使用している!

薬用ネオテクトは医薬部外品の有効成分「シメン5オール・フェノールスルホン酸亜鉛」のダブルでワキガや加齢臭などのニオイにアプローチします。
これらの成分は厚生労働省から効果を認められたもので、不快なニオイの原因となる根本から抑制する効果が期待できるものです。
ニオイが発生するのは汗を皮膚の常在菌が餌にして繁殖するため。
ニオイ菌を殺菌するシメンー5-オールは抗菌作用があり菌の増殖と汗を抑えることでニオイの発生を元から絶ちます。
薬用ネオテクトはニオイだけでなく原因となる汗にもアプローチするフェノールスルホン酸亜鉛を配合しており、毛穴を引き締めて制汗作用もしっかり期待できます。
とくにフェノールスルホン酸亜鉛は連続使用するほど制汗効果が高まるともいわれていますので、ニオイの悩みを根本から改善したい人ならさらに満足できるのではないでしょうか。
高密着テクノロジーで汗にも強い!
一般的な制汗剤はパウダーのスプレーや皮膚表面だけにとどまるスティックタイプなどがあり、なかなか防臭・制汗効果を実感できないのが現実です。
そんな点にこだわり開発された薬用ネオテクトはナノ化したマイクロクリームで肌にネット状でクリームが密着することが特徴。
膜を貼ったように汗を抑制しながらも有効成分がきちんと肌の奥まで到達しますので、さらにニオイ原因を抑制する肌コンディションへと改善されます。
またクリームはウォータープルーフになっているので効果の持続力も抜群。
朝塗っておけば夜まで臭わないというユーザーも多いですよね。
汗は放置すると雑菌が繁殖する原因になり、結果的には肌荒れにもつながります。
汗を何度も拭き取る摩擦は制汗剤で弱った肌にさらにデメリット。
薬用ネオテクトは長時間制汗と殺菌効果が持続し、さらっとした使用感も人気の理由です。
肌荒れが心配な人も安心して使える!

ムダ毛の処理が頻繁に行われるワキやデリケートゾーン。
脱毛サロンで処理している人も近年増えていますが、脱毛や除毛は肌のダメージ原因。
不安定なところに刺激の強い制汗剤をつければ肌荒れになるのは当然ですよね。
薬用ネオテクトが人気の理由は乾燥肌やダメージを受けた肌にも安心な天然由来エキス入りであること。
汗でバランスを崩すと肌環境が乱れますので、脱毛中の肌ならなおさら皮膚を保護することが必要。
薬用ネオテクトには防臭効果や制汗効果をサポートし肌を整える茶エキスやドクダミエキスなど、自然成分でアプローチできることも特徴。
保湿効果のあるプラセンタエキスやヒアルロン酸などフェイスケアレベルのうるおい成分まで配合されていますので、使うほど肌が綺麗になることもあるでしょう。
また肌を引き締めてキメを整える天然の有用成分も配合していますので、かゆみや肌の黒ずみ、乾燥などのトラブルにも対抗できます。
\ 初回限定 2,980円 /
薬用ネオテクトの使い方とニオイケアのポイントについて
薬用ネオテクトの優秀な成分を実感するためにも適切な使い方を守りましょう。
基本的なステップとニオイケアを効率的に行うポイントをまとめましたので参考にしてくださいね。
| カテゴリ | 説明 |
|---|---|
| 基本的な使い方 | 清潔な肌に約1~2㎝の量を取り、円を描くように塗る。朝と夜に使用。全身に対応。 |
| 使用のポイント | 塗布後、肌を抑えてマッサージ。デリケートゾーンでは粘膜に触れないよう注意。 |
| 使用頻度 | 朝と夜、汗をかく季節は塗りなおしも必要。 |
| 持ち運び | コンパクトで目立たないデザイン。外出先での塗りなおしに便利。 |
| ニオイケアの追加ポイント | 食生活の改善、ストレスの管理、適度な運動で体臭をコントロール。 |
| 注意点 | 粘膜に触れるとバランスが崩れる可能性あり。敏感肌はパッチテスト推奨。 |
使い方ステップについて

薬用ネオテクトの使い方手順は、清潔な肌に約1~2㎝ほどチューブから適量を取り出して気になるところに円を描くように塗るだけ。
テクスチャーは軽く伸びやすいので、ごしごし摩擦しなくてもさっと広がります。
塗布したら肌を抑え込みしっかりクリームをマッサージするように馴染ませましょう。
使い方の基本はたったこれだけ。
使用頻度は朝のお出かけ前と夜入浴後。
クリームを塗る際は必ず肌がきれいになっていることを確認しておきましょう。
薬用ネオテクトの使用部位はワキ・足・首もと・胸・背中・うなじ・デリケートゾーンなど全身に対応しています。
ただデリケートゾーンに使う場合は粘膜部分に入らないよう肌の表面だけに塗布してください。
殺菌成分が配合されているので粘膜についてしまうとバランスが崩れてしまう恐れがあるのでご注意くださいね。
薬用ネオテクトの使い方のコツについて
少量でもすぐに肌になじみべたつかないサラサラな使用感なので家族全員でご使用できます。
さらに効果を実感するためには汗をかきやすいシーズンは塗りなおしも必要に。
容器はコンパクトなシンプルなデザインなのでデオドラントだとわかることはありませんので、気になる方はぜひ携帯しておきましょう。
外出先で塗りなおす場合はまず塗布する部位をティシュなどで汗と汚れを拭き取り乾いた状態にしておくこと。
ワキに使うことが多いと思いますが、ワキの使用はくぼみだけでなく少し広い範囲でクリームをのばすとさらに防臭や制汗が効果的になります。
肌が敏感な方は最初にパッチテストをしておきましょう。
体臭ケアに加えるといいこと
ニオイケアはデオドラントの使用は欠かせないこと。
さらにサポートとして普段の生活内でもできることが色々ありますのでぜひプラスしてみましょう。
たとえば食生活、汗にふくまれるたんぱく質が多くなると菌の餌になりやすいため、肉食や油っぽい料理よりも野菜や果物などを中心してみましょう。
そしてストレスや疲労も体臭を強くする原因になるので生活リズムを整えることもおすすめ。
早寝早起き、快眠習慣、そして汗腺を活発にするために適度な運動習慣を持つことも有効です。
薬用ネオテクトの効果が期待したほどではなかったという場合は、このような面かもぜひアプローチしてみましょう。
薬用ネオテクトのメリット・デメリットがあるので理解してから購入しよう!

薬用ネオテクトのメリットとデメリットについてご紹介いたします。
デメリット
- ドラッグストアで売っていない
- 効果の持続力は個人差あり
- 1日2回塗布が必要
- 塗りなおしが必要な場合もあり
メリット
- 1本で全身のニオイケアに使える
- 伸びやすいテクスチャー
- サラサラの使用感なので夏も使える
- シンプルなデザイン容器
- 子供も使える安全設計
- 保湿成分入りで乾燥肌にもおすすめ
- 防臭と制汗ができる
- 効果効能が認められた有効成分入り
薬用ネオテクトをおすすめしない人はこんな方・よく考えてから判断!
おすすめしない人は次のような場合なのでご注意くださいね。
- 即効性を期待している
- 長く使う予定はない
- 使い方を守らない
- 毎日使わない
- アレルギー成分がある
- 安い制汗剤を探している
薬用ネオテクトをおすすめする人・こんな場合は満足!
おすすめする人は次のような方なのであてはまる人はぜひ挑戦してみてください。
- ワキガで悩んでいる
- 何か所かニオイが気になる
- 加齢臭が恥ずかしい
- 敏感肌なので心配
- なかなか効果がある商品が見つからない
- 本気で体臭ケアを始めたい
- クリームタイプに興味がある
- 定期購入をしたい
薬用ネオテクトの成分と副作用のリスクについて知っておきたいこと
薬用ネオテクトは色々な成分が入っていますので、副作用が少し心配な方もいると思います。
使用前に注意しておきたいことやリスクについてまとめましたので確認してからご利用くださいね。
| カテゴリ | 説明 |
|---|---|
| 配合成分 | 殺菌・制汗の有効成分2種、サポート成分、潤い成分が配合。全成分表は公式サイトで確認可能。 |
| 安全性 | 医薬部外品で有効成分は効果効能が認められている。国内工場で厳格に製造管理。 |
| アレルギーテスト | 7つの添加物フリーでアレルギーテスト済み。 |
| 副作用 | 特に副作用を招く成分は使用していないが、事前にパッチテスト推奨。 |
| 使用対象 | 大人はもちろん、お子様でも使用可能。 |
配合成分について
配合成分はプロ仕様の殺菌力が持続することをコンセプトにしたもので、殺菌・制汗の有効成分が2種とサポート成分、潤い成分などが配合されています。
医薬部外品のクリームで有効成分は効果効能が認められたものなので安心。
全成分表は公式サイトで確認できますのでアレルギーが気になる方は必ずチェックしておいてくださいね。
副作用について

副作用を招く成分は一切使用していませんが、肌との相性が心配な人は事前にパッチテストを行っておきましょう。
お子様でも使用できるよう7つの添加物フリーでアレルギーテスト済み。
高品質なプロレベルの制汗剤で国内工場で厳しく製造管理していることも安心して使える点になります。
薬用ネオテクトQ&Aのまとめ・よく寄せられる質問はこちら!

薬用ネオテクトを毎日快適に使えるよう、よく寄せられる疑問や質問をQ&A形式でまとめましたので、わからないことがあったらぜひ参考にしてください。
よくデオドラント商品で肌荒れになりますが使っても大丈夫でしょうか?
薬用ネオテクトは皮膚を保護して肌を安定させる天然由来エキスを配合していますので、使用を続けるほど肌がしっとりするという方もいるほどです。
ニオイケアと肌ケア一緒にできるのでご安心ください。
ワキガと診断されました。
薬用ネオテクトは医療機関で処方する薬とは違い、セルフケアで防臭と制汗をするデオドラントクリームです。
ワキガの方ももちろん使用できますが、担当医の指示にあわせて専門の治療も続けておきましょう。
ものすごい汗かきですが朝塗れば夜まで大丈夫ですか?
浸透しやすいマイクロサイズの成分になっていますので一般的なクリームよりも効果は持続しますが、
汗で効力が軽減することはありますので、気になったら汗をティッシュやタオルで拭き取りクリームを塗りなおしてお使いください。
1本でやめたらニオイはまたひどくなるでしょうか?
薬用ネオテクトは継続使用でさらに臭わない体へと変えていきますので、最低でも3ヶ月ぐらいは継続したほうがよいでしょう。
公式サイトの定期購入を利用されている方がとても多いのでお得に続けられます。
夜も絶対に塗らないとだめですか?
はい。1日朝と夜2回の塗布を推奨しています。
夜は寝ている間の汗と菌の繁殖を防ぐ目的がありますので、朝だけの使用だと効果があまり実感できないこともあると思います。
伸びがよいクリームなので1日2回使用しても1本でたっぷり1か月使えると思います。
薬用ネオテクトまとめ

ニオイの悩みは毎日続くので人も言えずひとりで苦しんでいる方も多いのではないでしょうか。
制汗剤はあらゆる種類がありますので、きちんとケアするには質の高いものがおすすめです。
薬用ネオテクトはランキングで1位を獲得しているほど高評価されている商品。
今まで効果を実感できるデオドラント商品に出会えなかった方も、薬用ネオテクトでやっと満足できると思いますよ。
\ 初回限定 2,980円 /
薬用ネオテクトの販売元情報
| 会社名 | 株式会社ヴィジョンステイト |
|---|---|
| 住所 | 〒170-0001 東京都豊島区西巣鴨4-1-7 東京本社ビル1F |
| 電話番号 | 050-3198-9458(営業時間 10:00-15:00) |
| 運営統括責任者 | 代表取締役: 渡邉 亙 |
| URL | https://brandnewstore.jp/ |
